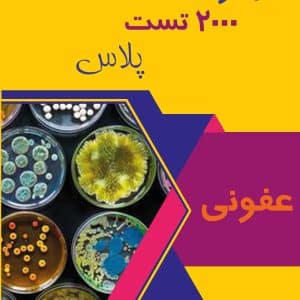
عفونی 2000 تست پلاس

ممکن است علاقهمند باشید به …
سبد خریدتان در حال حاضر خالی است.
تازه در فروشگاه
-
محصول تخفیف خورده
 جراحی ۲۰۰۰ تست پلاسقیمت اصلی تومان۱.۵۰۰.۰۰۰ بود.تومان۹۰۰.۰۰۰قیمت فعلی تومان۹۰۰.۰۰۰ است. هر ماه
جراحی ۲۰۰۰ تست پلاسقیمت اصلی تومان۱.۵۰۰.۰۰۰ بود.تومان۹۰۰.۰۰۰قیمت فعلی تومان۹۰۰.۰۰۰ است. هر ماه -
محصول تخفیف خورده
عفونی ۲۰۰۰ تست پلاسقیمت اصلی تومان۸۰۰.۰۰۰ بود.تومان۵۶۰.۰۰۰قیمت فعلی تومان۵۶۰.۰۰۰ است. هر سال
عفونی ۲۰۰۰ تست پلاسقیمت اصلی تومان۸۰۰.۰۰۰ بود.تومان۵۶۰.۰۰۰قیمت فعلی تومان۵۶۰.۰۰۰ است. هر سال -
محصول تخفیف خورده
 پکیج داخلی ۲۰۰۰ تست پلاسقیمت اصلی تومان۲.۸۰۰.۰۰۰ بود.تومان۱.۷۰۰.۰۰۰قیمت فعلی تومان۱.۷۰۰.۰۰۰ است. هر سال
پکیج داخلی ۲۰۰۰ تست پلاسقیمت اصلی تومان۲.۸۰۰.۰۰۰ بود.تومان۱.۷۰۰.۰۰۰قیمت فعلی تومان۱.۷۰۰.۰۰۰ است. هر سال -
محصول تخفیف خورده
 اشتراک کلیه ۲۰۰۰ تست پلاسقیمت اصلی تومان۵۰۰.۰۰۰ بود.تومان۳۰۰.۰۰۰قیمت فعلی تومان۳۰۰.۰۰۰ است. هر سال
اشتراک کلیه ۲۰۰۰ تست پلاسقیمت اصلی تومان۵۰۰.۰۰۰ بود.تومان۳۰۰.۰۰۰قیمت فعلی تومان۳۰۰.۰۰۰ است. هر سال
